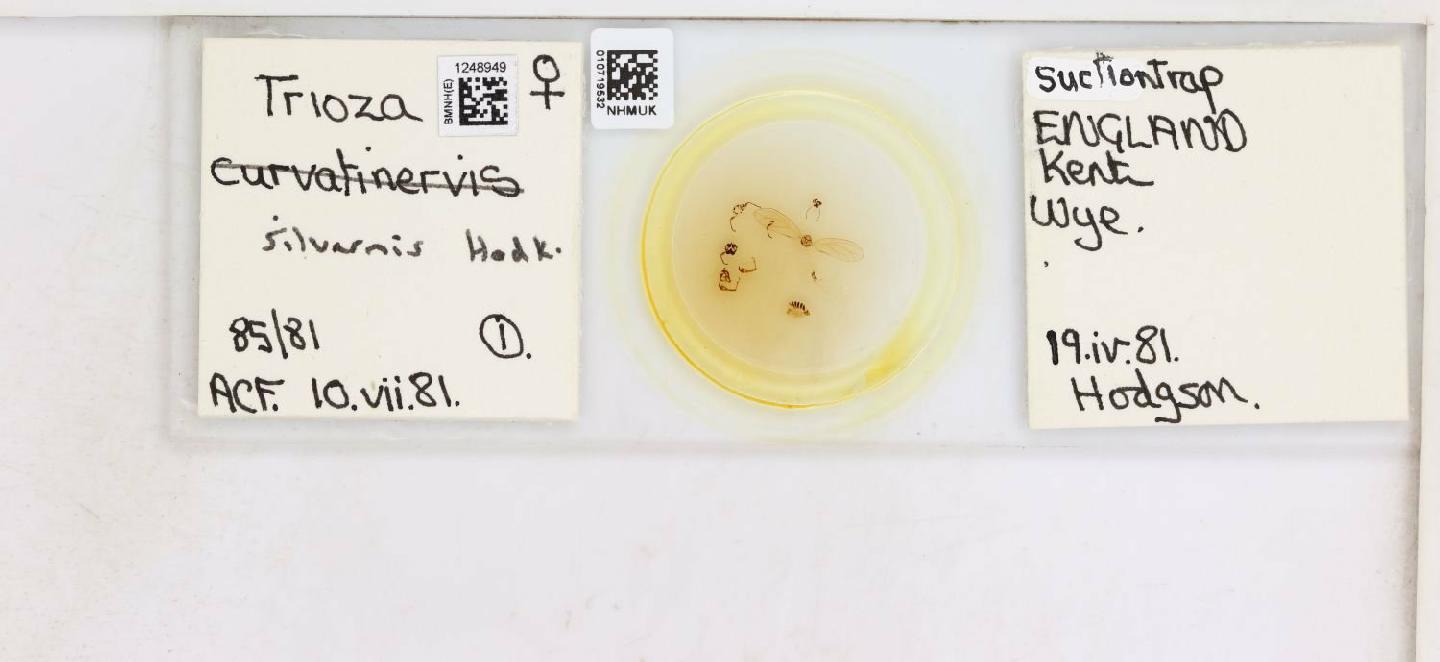

Espèces 2881 à 2896 sur 2929
Bactericera curvatinervis
Foerster, 1848
13 occurrences
13 medias

Bactericera femoralis
Foerster, 1848
35 occurrences
35 medias

Bactericera maura
Foerster, 1848
4 occurrences
4 medias

Bactericera nigricornis
Foerster, 1848
46 occurrences
46 medias

Bactericera perrisii
Puton, 1876
8 occurrences
8 medias

Bactericera salicivora
Reuter, 1876
33 occurrences
33 medias

Bactericera silvarnis
Hodkinson, 1974
4 occurrences
4 medias
Bactericera striola
Flor, 1861
16 occurrences
16 medias

Bactericera trigonica
Hodkinson, 1981
59 occurrences
59 medias

Eryngiofaga mesomela
Flor, 1861
25 occurrences
25 medias

Lauritrioza alacris
Flor, 1861
627 occurrences
627 medias

Phylloplecta trisignata
Löw, 1886
36 occurrences
36 medias

Trichochermes walkeri
Foerster, 1848
144 occurrences
144 medias

Trioza abdominalis
Flor, 1861
5 occurrences
5 medias

Trioza agrophila
Löw, 1888
1 occurrences
1 medias

Trioza anthrisci
Burckhardt, 1986
13 occurrences
13 medias
